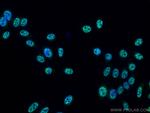
Phospho-mTOR (Ser2448) Antibody in Immunocytochemistry (ICC/IF)

Search
Proteintech
Phospho-mTOR (Ser2448) Monoclonal Antibody (2A12G3)
{{$productOrderCtrl.translations['antibody.pdp.commerceCard.promotion.promotions']}}
{{$productOrderCtrl.translations['antibody.pdp.commerceCard.promotion.viewpromo']}}
{{$productOrderCtrl.translations['antibody.pdp.commerceCard.promotion.promocode']}}: {{promo.promoCode}} {{promo.promoTitle}} {{promo.promoDescription}}. {{$productOrderCtrl.translations['antibody.pdp.commerceCard.promotion.learnmore']}}
产品信息
67778-1-IG
种属反应
已发表种属
宿主/亚型
分类
类型
克隆号
抗原
偶联物
形式
浓度
规格
纯化类型
保存液
内含物
保存条件
运输条件
产品详细信息
Aliquoting is unnecessary for -20°C storage.
靶标信息
FRAP1 (mTOR) is a serine/threonine kinase that plays a critical role in cellular growth and proliferation. Perturbations in the mTOR/PI3-kinase/AKT pathway are associated with numerous forms of cancer. FRAP1 is also the target of rapamycin and its analogues, which are currently used as immunosuppressants and cancer therapeutics. Mutations affecting the gene results in Smith-Kingsmore syndrome.
仅用于科研。不用于诊断过程。未经明确授权不得转售。
生物信息学
蛋白别名: angiopoietin-like factor CDT6; FK506 binding protein 12-rapamycin associated protein 1; FK506 binding protein 12-rapamycin associated protein 2; FK506-binding protein 12-rapamycin complex-associated protein 1; FKBP-rapamycin associated protein; FKBP-rapamycin associated protein (FRAP); FKBP-rapamycin-associated protein FRAP; FKBP12-rapamycin complex-associated protein; FKBP12-rapamycin complex-associated protein 1; m-TOR; Mammalian target of rapamycin; Mechanistic target of rapamycin; mechanistic target of rapamycin (serine/threonine kinase); mTOR; mTORC1; Rapamycin and FKBP12 target 1; rapamycin associated protein FRAP2; Rapamycin target protein 1; RAPT1; Serine/threonine-protein kinase mTOR; Tyrosine-protein kinase mTOR; unnamed protein product
基因别名: 2610315D21Rik; AI327068; flat; FRAP; FRAP1; FRAP2; MTOR; RAFT1; RAPT1; SKS
UniProt ID: (Human) P42345, (Mouse) Q9JLN9
Entrez Gene ID: (Human) 2475, (Mouse) 56717